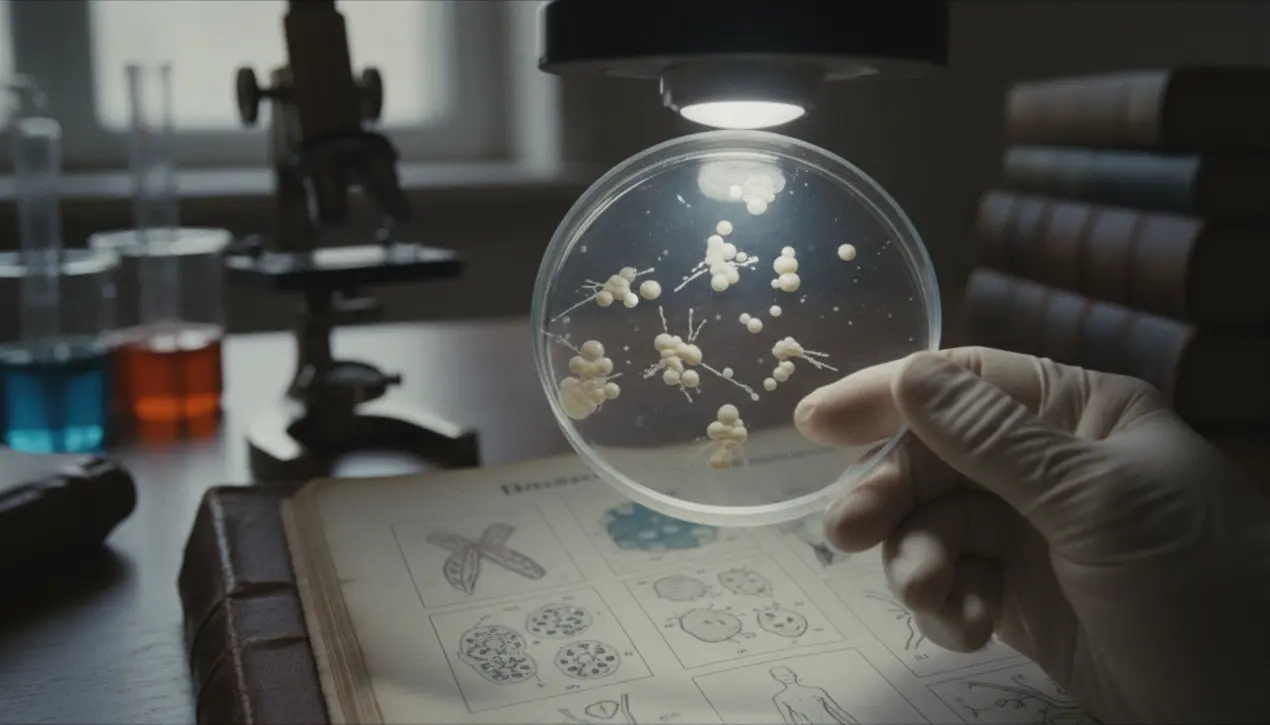
post-main

SciencemedicineInfectious Diseases
The Medical Rarity of Penile Tuberculosis: A Clinical Deep Dive
KE
Kevin White
17 hours ago7 min read4 comments
Tuberculosis (TB) is a disease most commonly associated with the lungs, but in rare instances, the bacterium Mycobacterium tuberculosis can manifest in extraordinary locations, including the penis. This condition, known as genital tuberculosis, represents a minute fraction of extrapulmonary TB cases and serves as a stark reminder of the pathogen's ability to disseminate throughout the body.Typically, the bacilli travel via the bloodstream or lymphatic system from a primary site of infection, often the lungs, to seed secondary infections in distant organs. When it involves the penis, the presentation is frequently mistaken for more common urological ailments, such as sexually transmitted infections, Peyronie's disease, or even cancer.Symptoms can include persistent ulcers, painful nodules, swelling, or penile deformity, creating a significant diagnostic challenge for clinicians. Confirmation often requires a high index of suspicion and specialized diagnostic tools like tissue biopsy for histopathology or polymerase chain reaction (PCR) testing, as standard sputum tests are ineffective for these isolated infections.The penis is a highly unusual site for TB, as the bacteria thrive in oxygen-rich environments like the lungs. Treatment follows the standard multi-drug regimen used for all forms of TB, involving a combination of antibiotics like isoniazid and rifampin over several months.However, the psychological impact and potential for functional complications can be severe, affecting a patient's quality of life and intimate relationships in ways that pulmonary TB does not. These rare cases underscore the persistent global threat of tuberculosis, which infects millions each year and is increasingly complicated by drug-resistant strains. For the medical community, penile TB is a compelling lesson in atypical disease presentation, emphasizing the need for comprehensive diagnostic approaches to a pathogen that remains a major public health concern worldwide.
#tuberculosis
#rare case
#penis
#medicine
#infectious diseases
#editorial picks news
Stay Informed. Act Smarter.
Get weekly highlights, major headlines, and expert insights — then put your knowledge to work in our live prediction markets.
Related News
Comments
Loading comments...
© 2025 Outpoll Service LTD. All rights reserved.